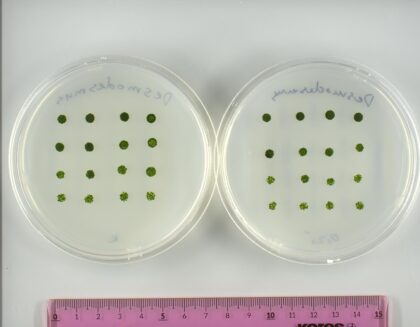

Evropská kosmická agentura (ESA) v České republice podpoří realizaci 13 českých vědeckých a technologických experimentů, které budou součástí připravované mise českého astronauta ve výcviku Aleše Svobody na Mezinárodní vesmírnou stanici (ISS). Najdeme mezi nimi například výzkum chování imunitního systému a nádorového bujení v mikrogravitaci nebo světově první projekt v oblasti nanorobotiky zaměřený na testování mikrorobotů ve vesmíru. Detailní představení experimentů se uskutečnilo u příležitosti konání největšího tuzemského festivalu kosmických aktivit, Czech Space Weeku.

Zdroj: Archiv Aleše Svobody
Mimořádný zájem o možnost zúčastnit se české mise na ISS projevily univerzity, výzkumné ústavy i firmy z celé republiky. Do úvodní výzvy se přihlásilo 70 návrhů, což početně odpovídá zhruba 4× většímu Polsku. To je jasný důkaz, jaký je hlad mezi výzkumnými institucemi po výzkumu na ISS. V následné výzvě k podání detailních návrhů z 25 předložených nakonec uspělo 13 nejperspektivnějších experimentů s ohledem na vědecký přínos, technickou proveditelnost i bezpečnost provozu na stanici. Právě silná poptávka po českém výzkumu na ISS se stala jedním z impulzů pro vznik národního projektu Česká cesta do vesmíru.
„Získat kontrakt ESA není otázkou jednoho posouzení, ale celého procesu, který zahrnuje několik kol odborného hodnocení,“ vysvětlil Ondřej Rohlík, manažer programu a delegát České republiky do programové rady ESA pro pilotované lety, mikrogravitaci a průzkum vesmíru a dodává: „České týmy musely prokázat, že jejich experimenty mají vysokou vědeckou hodnotu a zároveň splňují přísné technické i bezpečnostní požadavky. Nyní začínají pracovat na prototypech, které bude ESA znovu hodnotit z hlediska připravenosti pro integraci do systémů ISS. Teprve poté vzniknou finální letové kusy určené pro samotnou misi.“ Vybrané špičkové projekty nejsou jednostranně zaměřené, ale reprezentují široké spektrum českého výzkumu – od biomedicíny, přes nanotechnologií a biochemii až po materiálové inženýrství a vzdělávací aktivity pro školy. Na jejich přípravě spolupracují univerzity, výzkumné instituce i firmy z celé republiky, mimo jiné Masarykův onkologický ústav, VŠB–Technická univerzita Ostrava, ČVUT v Praze, Univerzita Karlova, Mendelova univerzita v Brně, Univerzita Palackého v Olomouci, Masarykova univerzita, VUT v Brně, BIOCEV, TRL Space, S.A.B. Aerospace a další.
Národní mise představuje pro české vědce jedinečnou a časově omezenou příležitost, jak své experimenty skutečně dostat na palubu ISS. V rámci běžných programů ESA mají menší státy, jako je právě Česká republika, jen omezené možnosti zapojení. Schvalování projektů může trvat až 10 let – déle, než bude stanice vůbec v provozu. Provoz ISS má být ukončen v roce 2030, takže prostor pro nové výzkumy se uzavírá už v následujících letech. Navíc, Česká národní mise přinese na ISS více domácích vědeckých experimentů než všechny předchozí mise dohromady. Zatímco v běžných programech ESA má Česko kvůli nižším příspěvkům omezený prostor, národní mise umožňuje naplno využít domácí potenciál – a to i rychleji.

„Tyto experimenty pro mě nejsou jen vědeckými projekty, ale i ukázkou obrovského nasazení lidí, kteří stojí za českou vědou. Bude pro mě čest nést výsledky práce našich vědců na palubu ISS a přispět tak k výzkumu, který může mít konkrétní přínos pro budoucí mise i pro život na Zemi,“ říká Aleš Svoboda, budoucí český astronaut, který právě dokončuje druhou ze tří etap základního astronautského výcviku ve výcvikovém středisku ESA v Kolíně nad Rýnem. Kromě vědeckého přínosu má česká mise i výrazný vzdělávací rozměr. Technické a přírodovědné obory dnes v České republice tvoří přibližně čtvrtinu všech vysokoškolských absolventů, zatímco v zemích s podobnou průmyslovou strukturou, jako je Německo, jde o více než třetinu. Zkušenosti ze zahraničí přitom ukazují, že právě vesmírné mise mohou zájem o STEM obory významně posílit.
„Ve Švédsku nebo Polsku po oznámení mise jejich astronautů vzrostl počet přihlášek na technické univerzity o desítky procent. I česká mise má podobný potenciál: může ukázat mladým lidem, že věda a technologie mají smysl, a že i z České republiky se dá dělat výzkum s globálním dopadem. Pokud se nám podaří probudit u mladých lidí zájem o techniku, fyziku nebo biologii, bude z toho těžit nejen věda, ale i celý náš průmysl. A právě proto považuji tuto misi za mimořádně důležitou investici do budoucnosti,“ zhodnotil Martin Kupka, ministr dopravy. Na podporu těchto cílů vznikla i celonárodní iniciativa Česká cesta do vesmíru, která propojuje vědu, vzdělávání a průmysl a posiluje české zapojení do kosmických aktivit. Projekt nezahrnuje pouze přípravu mise Aleše Svobody, ale také vzdělávací projekty, které mladé lidi přivádějí blíž ke světu kosmického průmyslu a výzkumu. Patří mezi ně například výběr mladých ambasadorů českého kosmického programu nebo jejich společný parabolický let, jenž symbolicky propojuje vědeckou přípravu s inspirací nové generace techniků, inženýrů a vědců. Pojďme si ale nyní podrobněji představit zmíněných 13 vědeckých projektů. Jejich prvotní extrémně stručné představení proběhlo už letos v dubnu, ale od té doby se ještě řada věcí zpřesnila.
Zdroj: Mendelova univerzita v Brně
AstroDesmus – Mikroskopické řasy jako nástroj pro budoucí těžbu kovů a přežití na Marsu
Pokud má jednou lidstvo žít na Měsíci či Marsu, nebude možné dovážet ze Země úplně všechno. Vědci proto již dnes hledají způsob, jak využít tamní zdroje a snaží se vyvinout pokročilé systému pro podporu života mimo naši planetu. Řešení na tento problém chce najít experiment AstroDesmus, jehož cílem je zjistit, zdali by mikroskopické řasy Desmodesmus armatus mohly fungovat jako nástroj pro budoucí těžbu kovů a přežití na Marsu. Projekt tak představuje nejen významný krok k soběstačným misím, ale také zároveň k čistším vodám a surovinám tady na Zemi. Mechanismy ověřené ve vesmíru lze totiž využít i pro šetrnou sanaci důlních vod, průmyslových areálů a recyklaci kovů z odpadů.
Za projektem stojí Mendelová univerzita Brno, Extremo Technologies a ICE Cubes Services.
AstroMoWe – Chytrá nositelná elektronika k monitorování pohybu a svalové aktivity astronautů na ISS
Astronauti vystavení mikrogravitaci mohou během jediného měsíce přijít až o 30 % svalové hmoty. Pravidelné a intenzivní denní cvičení jsou tak nutností, aby fyzický stav astronautů po dlouhodobém pobytu ve vesmíru neodpovídal kondici osmdesátiletého jedince. Proto je nezbytné detailně sledovat změny svalové aktivity a pohyb astronautů v mikrogravitaci, aby bylo možné optimalizovat tréninkové programy a minimalizovat zdravotní rizika spojená s dlouhodobými vesmírnými misemi. Řešení tohoto problému chce najít experiment AstroMoWe, který ve spolupráci s Evropskou vesmírnou agenturou (ESA) vyvíjí chytré nositelné senzory pro měření elektromyografické (EMG) a pohybové aktivity astronautů.
Za projektem stojí ČVUT v Praze, Západočeská univerzita v Plzni, G.L. Electronic a VÚB

Zdroj: Masarykův onkologický ústav
CANCER – Predikce rakoviny ještě předtím, než se objeví příznaky
Jak lidské tělo reaguje na mikrogravitaci, fyzickou i psychickou zátěž nebo radiační prostředí? Nové poznatky v tomto směru chce přinést experiment CANCER, který představuje unikátní propojení kosmické medicíny a molekulární onkologie. Zjištěné výsledky budou mít význam nejen pro budoucí kosmické lety, ale i pro běžnou medicínu – zejména v oblasti neinvazivní diagnostiky, monitorování imunity a predikce onemocnění souvisejících se stresem a stárnutím, mezi které patří například onkologická onemocnění.
Za projektem stojí Masarykův onkologický ústav.
CONREX – Nanoroboti pro biomedicínu
CONREX bude vůbec prvním experimentem světa v oblasti nanorobotiky, který bude realizován na oběžné dráze za účelem testování nanorobotů a mikrorobotů jako inovativního nástroje pro odstraňování biofilmů nejen v prostředí vesmíru. Experiment přímo přispívá k bezpečnějším, čistším a udržitelnějším dlouhodobým misím, a zároveň nabízí významný aplikační potenciál na Zemi – v medicíně, např. při léčbě nádorových onemocnění, průmyslu i ochraně životního prostředí, kde nanoroboti dokáží čistit např. filtrační systémy. Česká nanorobotika se tak díky tomuto projektu stává nedílnou součástí světového budoucího vesmírného výzkumu s výrazným vedením v oblasti nanorobotické biomedicíny.
Za projektem stojí VŠB – TUO a TRL Space.

Zdroj: RNDr. Linda Nedbalová
CryoAlgae – Mikrořasy zdrojem životní podpory vesmírných misí
Experiment CryoAlgae otestuje dva unikátní kmeny mikrořas získaných z extrémního prostředí s cílem vyhodnotit, zda mohou efektivně produkovat cenné látky jako polynenasycené mastné kyseliny a zjistit, jak se mění jejich metabolismus v podmínkách mikrogravitace. Projekt významně přispěje k vývoji uzavřených systémů životní podpory pro budoucí vesmírné mise, kde mikrořasy mohou zajišťovat produkci kyslíku, čištění vzduchu a vody a produkci potravin s vysokou nutriční hodnotou pro posádku. Získané poznatky najdou využití i na Zemi díky bližšímu zkoumání stresové odpovědi mikrořas posun v inovacích v biotechnologii, zemědělství, čištění vody a pohlcování uhlíku. Experiment navazuje na průkopnický výzkum československého kosmonauta Vladimíra Remka v roce 1978, který jako první Čech provedl biologické experimenty ve vesmíru na stanici Saljut 6.
Za projektem stojí Přírodovědecká fakulta Univerzity Karlovy.
CZPAD – Aktivní dozimetrický systém pro mise do hlubokého vesmíru
Experiment CZPAD (Czech Personal Active Dosimeter) představuje jedinečnou příležitost, jak ověřit osobní dozimetr za reálných podmínek při nasazení v kosmickém prostředí. Cílem experimentu je otestovat schopnost zařízení přesně měřit dávku záření, včetně příspěvku neutronové složky, a umožnit v reálném čase odhad osobní dávky. Unikátní je zejména technika měření neutronů, ve které bude hrát roli i tělo astronauta. Experiment přispěje k rozvoji metod aktivní osobní dozimetrie pro dlouhodobé mise, například na Měsíc nebo Mars. Nové poznatky o interakci neutronů s lidským tělem mohou být využity i v pozemských aplikacích – například v letecké dopravě, jaderné energetice či zdravotnictví, kde se řeší podobné problémy s dozimetrií v polích směsného záření.
Za projektem stojí Ústav jaderné fyziky AV ČR, v. v. i. a UST (Universal Scientific Technologies s.r.o.).

Zdroj: NASA
EDOUTA – Vzdělávání z Mezinárodní vesmírné stanice
EDOUTA (Education and Outreach Activities of the Czech Astronaut on Board the ISS) je ucelený projekt vzdělávacích a popularizačních aktivit, které využijí misi českého astronauta na Mezinárodní kosmické stanici ISS jako mimořádnou příležitost pro inspiraci dětí, studentů i veřejnosti. Jde o vůbec první soubor takto komplexních edukačních výstupů propojených přímo s pilotovanou kosmickou misí v českém prostředí. Cílem projektu je podpořit zájem mladé generace o přírodní vědy, techniku, vesmír a ochranu planety, a to prostřednictvím sedmi provázaných tematických okruhů.
Za projektem stojí Planetum & Vzdělávací kancelář ESA-ESERO ČR, Psychologický ústav AV ČR, Astronomický ústav AV ČR,
ICARUS ARMOR Next Gen – Digitální dvojče pro předpovídání kognitivního výkonu (nejen) astronautů
Jak nejlépe připravit kognitivní výkonnost astronauta pro misi na Mezinárodní vesmírnou stanici (ISS)? Řešení na tuto odpověď bude hledat experiment ICARUS ARMOR Next Gen, jehož cílem je během letové mise Aleše Svobody na ISS shromáždit data pro personalizované AI digitální dvojče. Technologie má význam nejen pro monitorování zdraví astronautů, při přípravě na misi a během ní, ale má přesah i do pozemského využití v náročných profesích jako jsou: hasiči, záchranáři, policisté nebo zdravotníci.
Za projektem stojí UptimAI, Lightly Technologies, VUT v Brně, Mendelova univerzita v Brně, University of Pennsylvania, Univerzita Karlova a Axiom Space

Zdroj: David Konečný
ISS T-shirt – Chytré tričko pro monitorování stresu astronauta
Cílem experimentu je vytvořit chytré tričko, které bude při kosmickém letu sledovat tělesný stav astronautů. Zvládne kontinuálně měřit dostupné fyziologické parametry a vypočítat tzv. stresovou entropickou zátěž (SEL) – novou termodynamickou metriku vyvinutou na Masarykově univerzitě, která dokáže kvantifikovat zátěž organismu. Technologie astronauta včas upozorní na možná rizika, jako je výrazná únava, metabolická nestabilita apod. Získané poznatky budou přenositelné i do zdravotnictví, krizových profesí, sportu a bezpečnosti práce. Umožní přesnější sledování stresu, prevenci a včasný zásah pro předcházení závažnějších následků. Projekt zároveň akceleruje vývoj nositelných systémů a datové analytiky napříč sektory.
Za projektem stojí Masarykova univerzita, Fakulta sportovních studií (MUNI, FSpS), VŠB – Technická univerzita Ostrava (VŠB-TUO), EGMedical, s.r.o. a G. L. Electronic, s.r.o.
METRO – Efektivní kosmické fotobioreaktory pro výrobu kyslíku a potravin
Zajistit soběstačnost posádek ve vesmíru je jedna ze současných výzev. K jejímu řešení může přispět také český experiment METRO, který bude zkoumat řízení přenosu plynů v mikrogravitaci pro efektivní dlouhodobý provoz kosmických fotobioreaktorů. Ty by mohly v budoucnu zajistit astronautům nepřetržitou výrobu kyslíku a potravin z oxidu uhličitého a vody.
Za projektem stojí České vysoké učení technické v Praze, Ústav chemických procesů AV ČR, v. v. i., esc Aerospace s.r.o. a Serenity Valley Technologies s.r.o.
PROTOCELL – Vznik života na Zemi a možná i jinde ve vesmíru
Je život ve vesmíru vzácný nebo se naopak vyskytuje skoro všude? Odpověď na tuto otázku hledá projekt PROTOCELL Dr. Kláry Hlouchové, který vzniká v Ústavu organické chemie a biochemie AV ČR. Vědci se v experimentu zaměří na tzv. protobuňky — předchůdkyně dnešních buněk. Pokud se ukáže, že protobuňky vznikají i ve stavu mikrogravitace, otevírá se možnost, že zárodek života mohl vzniknout i mimo naši planetu.
Za projektem stojí Ústav organické chemie a biochemie AV ČR a Yuri GmbH
PUMR-B – Pěstování rostlin mimo naši planetu
Nový, ambiciózní, vědecký experiment PUMR-B řeší kritickou roli, kterou budou hrát rostliny při udržování lidského života ve vesmíru. Jeho cílem je detailně prostudovat fyziologické a molekulární změny, kterými prochází ječmen jarní při růstu v prostředí mikrogravitace a zároveň pro pěstování této plodiny ve vesmíru vyvinout specializovaný bioreaktor. Poznatky z projektu přinesou cenné využití i na Zemi. Mikrogravitace působí jako silný stresor, což může odhalit dosud neznámé molekulární dráhy spojené se stresovou reakcí rostlin. Tato nová zjištění mohou následně pomoci při šlechtění odolnějších odrůd ječmene vůči suchu a horku a přispět tak ke globální potravinové bezpečnosti.
Za projektem stojí S.A.B. Aerospace s.r.o. a Český institut výzkumu a pokročilých technologií / Czech Advanced Technology and Research Institute (CATRIN) Univerzity Palackého v Olomouci.

Zdroj: SAB Aerospace
ZOE – Ověří schopnost rozmnožování ve vesmíru
Je možné, aby se v podmínkách mikrogravitace a kosmické radiace vyvinul plodný jedinec? Odpověď na tuto otázku bude ověřovat biologický experiment ZOE. Tento projekt může významně přispět k pochopení reprodukční biologie i mimo naši planetu. I přesto, že experiment bude probíhat na modelu kura domácího, výsledky lze aplikovat i na savce, tedy i člověka. Vědci budou moci na jejich základě a odhalení případných patologií určit, co je potřeba překlenout biotechnologickými metodami a zajistit tak bezproblémový embryonální vývoj vedoucí k vývoji pohlavně plodného jedince.
Za projektem stojí Ústav jaderné fyzicky AV ČR, v.v.i, GODS s.r.o. a Universal Scientific Technologies s.r.o.
Jednotlivé experimenty jsme si dnes představili jen velmi stručně, ale příští týden začne na našem webu vycházet seriál, který se podrobněji zaměří na jednotlivé projekty i na výzkumníky, kteří za nimi stojí.
Zdroje informací:
Tisková zpráva
Zdroje obrázků:
Aleš Svoboda
Tisková zpráva
Tak tohle mě „posadilo“. Nejen naprosto skvělý souhrn projektů, ale nakonec i příslib de facto seriálu s představením do větších podrobností. Děkuju moc a těším se neskutečně.
A pokud by to šlo (bylo v lidských silách), moc bych se přimlouval, aby u každého projektu bylo i napsáno, na jaký už proběhlý výzkum navazuje, jakou mají spolupráci (i mezinárodní), jak se nové výzkumy budou moci použít zase dál, navázat na ně.
Jaký je postoj nové politické garnitury k tomuhle projektu a letu Aleše?
sledoval jsem online včerejší tiskovku, k tomu experimentu ZOE jste mohli připsat, že na ISS poletí opravdu česká vejce .) já už jsem to včera dával k dobru na fóru coby vtípek narážející na slavnou slepici v seriálu Kosmo, slepice neletí, ale že se do takto úzkého výběru dostal vědecký projekt studující kura domácího, resp. vejce, to považuju za krásné kouzlo (ne)chtěného? .))
Libi se mi otazka pestovani jecmene ve vesmiru…zkratka experimentu PUMR tedy znamena Pilsner Urquell Microgravity Reactor?😉
😉
Phenotyping Unit for Microgravity Research – Assessing the Early Development of Barley